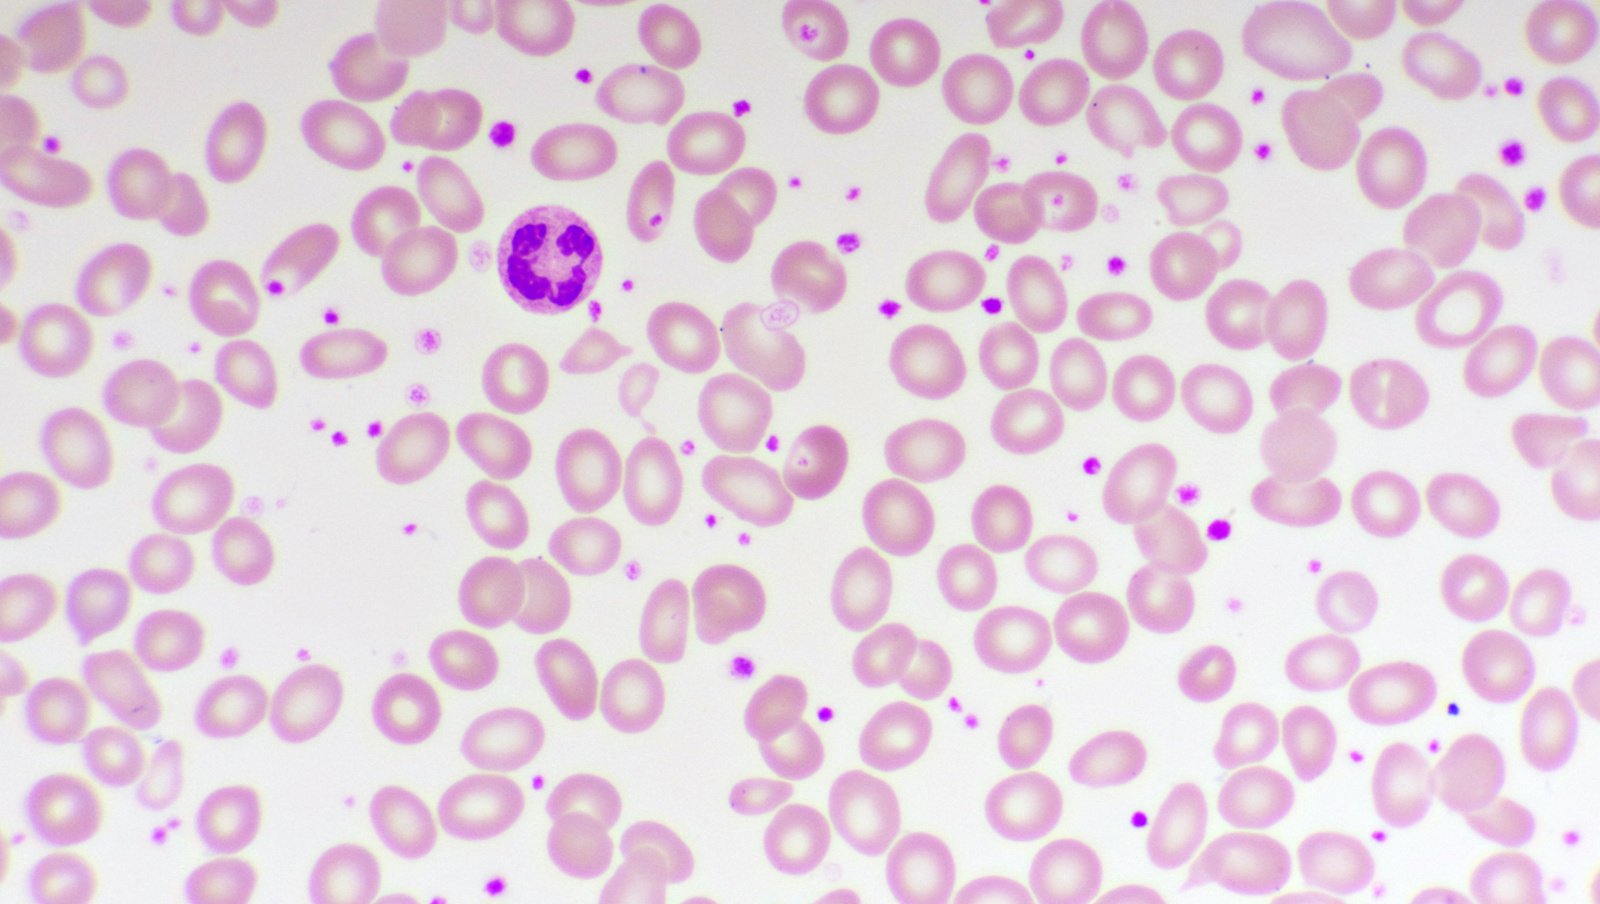
Nadpłytkowość u dzieci i młodzieży — klasyfikacja, podejście diagnostyczne i postępowanie terapeutyczne

Nadpłytkowość jest częstą nieprawidłowością wykrywaną przypadkowo w badaniach morfologicznych krwi, wykonywanych z innego powodu. Zazwyczaj przebiega bezobjawowo, związana jest z przemijającymi czynnikami i ustępuje wraz z ich eliminacją. U dzieci wtórna trombocytoza najczęściej wywołana jest zakażeniem lub procesami zapalnymi. Rzadko może mieć jednak charakter pierwotny.
Materiał przeznaczony wyłącznie dla pracowników służby zdrowia
Ten materiał jest dostępny dla zarejestrowanych użytkowników.
Zaloguj się
Szanowni użytkownicy,
część materiałów udostępnianych na naszym portalu jest przeznaczona
wyłącznie dla lekarzy.
Wynika to z regulacji prawnych, do których musimy się stosować.
Jeśli nie jesteś lekarzem, zachęcamy do korzystania z przygotowanych przez nas materiałów dostępnych w zakładce dla pacjentów.







